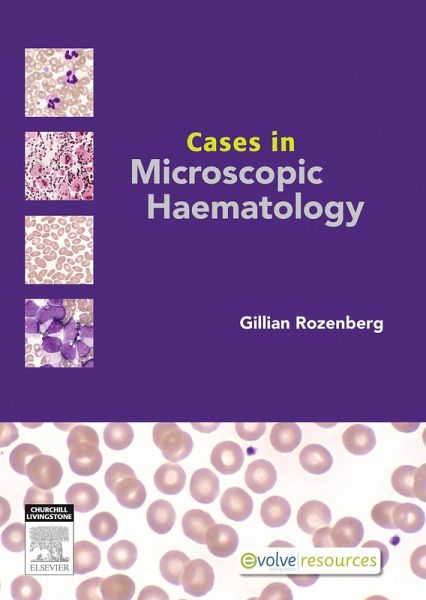

Cases in Microscopic Haematology - E-Book (eBook, ePUB)
PAYBACK Punkte
23 °P sammeln!
An engaging haematology textbook detailing the laboratory process of data and blood film analysis, differential diagnosis and reporting.Cases in Microscopic Haematology is a high-quality haematology textbook featuring a collection of microscopic haematology case studies.Author Gillian Rozenberg has selected 80 case studies specifically designed to engage the reader in the laboratory process of data and blood film analysis, differential diagnosis and reporting. This selection includes a range of rare blood film/slides for an additional challenge.Case studies are organised according to difficult...
An engaging haematology textbook detailing the laboratory process of data and blood film analysis, differential diagnosis and reporting.
Cases in Microscopic Haematology is a high-quality haematology textbook featuring a collection of microscopic haematology case studies.
Author Gillian Rozenberg has selected 80 case studies specifically designed to engage the reader in the laboratory process of data and blood film analysis, differential diagnosis and reporting. This selection includes a range of rare blood film/slides for an additional challenge.
Case studies are organised according to difficulty and the worked cases are available in the back of the textbook.
Each case featured in Cases in Microscopic Haematology provides the family history, analyser data and blood film/slide. Students are able to work through the cases using a template to complete the differential diagnosis and reporting. Both the process and template simulate a functioning laboratory environment.
This local publication will appeal to both the academic and professional market. It is an excellent companion to Microscopic Haematology: A Practical Guide for the Laboratory 3e - also by Gillian Rozenberg.
Elsevier's Evolve platform features a range of resources for instructors. This includes all the book's images in an easy-to-use image collection and 20 annotated virtual slides comprising case studies from Cases in Microscopic Haematology.
. 20 annotated virtual Haematology slides . 80 Haematology cases to be worked through using template . Simulate laboratory process . Include rare range of blood film/slides not easily accessible (including paediatric)
Evolve Resources For instructors only: . Image Collection - all the images from the book . 20 Virtual Slides - featuring cases from the book o Virtual Slide Annotations
Cases in Microscopic Haematology is a high-quality haematology textbook featuring a collection of microscopic haematology case studies.
Author Gillian Rozenberg has selected 80 case studies specifically designed to engage the reader in the laboratory process of data and blood film analysis, differential diagnosis and reporting. This selection includes a range of rare blood film/slides for an additional challenge.
Case studies are organised according to difficulty and the worked cases are available in the back of the textbook.
Each case featured in Cases in Microscopic Haematology provides the family history, analyser data and blood film/slide. Students are able to work through the cases using a template to complete the differential diagnosis and reporting. Both the process and template simulate a functioning laboratory environment.
This local publication will appeal to both the academic and professional market. It is an excellent companion to Microscopic Haematology: A Practical Guide for the Laboratory 3e - also by Gillian Rozenberg.
Elsevier's Evolve platform features a range of resources for instructors. This includes all the book's images in an easy-to-use image collection and 20 annotated virtual slides comprising case studies from Cases in Microscopic Haematology.
. 20 annotated virtual Haematology slides . 80 Haematology cases to be worked through using template . Simulate laboratory process . Include rare range of blood film/slides not easily accessible (including paediatric)
Evolve Resources For instructors only: . Image Collection - all the images from the book . 20 Virtual Slides - featuring cases from the book o Virtual Slide Annotations
Dieser Download kann aus rechtlichen Gründen nur mit Rechnungsadresse in A, B, BG, CY, CZ, D, DK, EW, E, FIN, F, GR, HR, H, IRL, I, LT, L, LR, M, NL, PL, P, R, S, SLO, SK ausgeliefert werden.